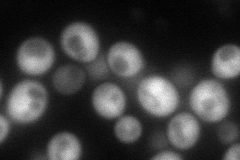
YJR135W-A
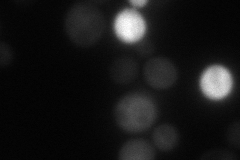
YJR135W-A
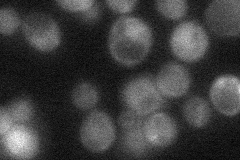
YJR135W-A

View description
Mitochondrial intermembrane space protein, forms a complex with Tim13p that delivers a subset of hydrophobic proteins to the TIM22 complex for inner membrane insertion; homolog of human TIMM8A, implicated in Mohr-Tranebjaerg syndrome
Localization:
Intensity:
Fold change:
Significance:
-
C’ GFP library in SD

below threshold18.28 -
N' NOP1pr-GFP in SD
cytosol92.0561 -
N' TEF2pr-mCherry in SD
cytosol36.8597 -
N' NATIVEpr-GFP in SD
below threshold28.0751 -
N' TEF2pr-VC and Cyto-VN in SD

mitochondria28.6926 -
C’ GFP library in SD+DTT

cytosol17.760.97No -
C’ GFP library in SD+H2O2

cytosol16.570.9No -
C’ GFP library in Starvation Media

cytosol15.080.82No -
C’ GFP library on the background of Pup2-DaMP

below threshold -
C’ GFP library on the background of CCT mutant

below threshold16.01280.875644No
